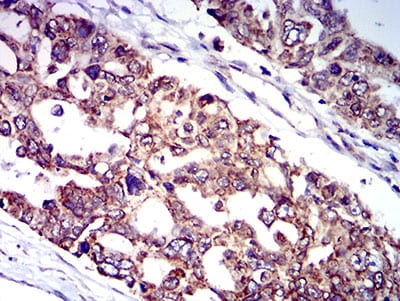

Mouse Monoclonal Antibody to CD129
货号:
31412
别名:
IL9R; IL-9R
应用:
WB,IHC,FCM
反应种属:
Human,Rat
抗体类型:
Primary antibody
Swissprot:
Q01113
规格:
目录价
在线咨询
Description |
|---|
The protein encoded by this gene is a cytokine receptor that specifically mediates the biological effects of interleukin 9 (IL9). The functional IL9 receptor complex requires this protein as well as the interleukin 2 receptor, gamma (IL2RG), a common gamma subunit shared by the receptors of many different cytokines. The ligand binding of this receptor leads to the activation of various JAK kinases and STAT proteins, which connect to different biologic responses. This gene is located at the pseudoautosomal regions of X and Y chromosomes. Genetic studies suggested an association of this gene with the development of asthma. Multiple pseudogenes on chromosome 9, 10, 16, and 18 have been described. Alternatively spliced transcript variants have been found for this gene. |
References |
|---|
| 1.Oncol Rep. 2015 Aug;34(2):795-802. 2.Int J Clin Exp Pathol. 2013 Apr 15;6(5):911-6. |
Specification |
|
|---|---|
| Aliases | IL9R; IL-9R |
| Entrez GeneID | 3581 |
| Swissprot | Q01113 |
| clone | 4A11H2 |
| WB Predicted band size | 57.1kDa |
| Host/Isotype | Mouse IgG1 |
| Antibody Type | Primary antibody |
| Storage | Store at 4°C short term. Aliquot and store at -20°C long term. Avoid freeze/thaw cycles. |
| Species Reactivity | Human,Rat |
| Immunogen | Purified recombinant fragment of human CD129 (AA: extra 41-270) expressed in E. Coli. |
| Formulation | Purified antibody in PBS with 0.05% sodium azide |
Application |
|
|---|---|
| WB | 1/500 - 1/2000 |
| IHC | 1/200 - 1/1000 |
| FCM | 1/200 - 1/400 |
| ELISA | 1/10000 |
Product Image
-
Black line: Control Antigen (100 ng);Purple line: Antigen (10ng); Blue line: Antigen (50 ng); Red line:Antigen (100 ng)

-
Western blot analysis using CD129 mouse mAb against C6 (1) and PC-3 (2) cell lysate.

-
Flow cytometric analysis of Ramos cells using CD129 mouse mAb (green) and negative control (red).

-
Immunohistochemical analysis of paraffin-embedded human cervical cancer tissues using CD129 mouse mAb with DAB staining.

-
Immunohistochemical analysis of paraffin-embedded human ovarian cancer tissues using CD129 mouse mAb with DAB staining.

鄂公网安备42018502007531号
鄂公网安备42018502007531号

